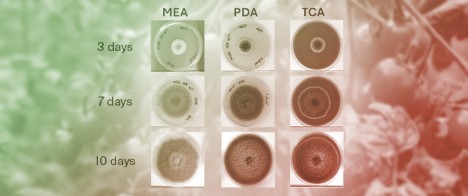
From Surface Colonies to Internal Contamination: A Comprehensive Investigation of <em>Alternaria alternata</em> Growth, Toxinogenesis, and Mycotoxin Migration Dynamics in Cherry Tomato Fruit Matrix

-
 Clostridioides difficile Immunity During Pregnancy and Passive Antibody Transfer to Neonates from Cord Blood and Breast Milk
Clostridioides difficile Immunity During Pregnancy and Passive Antibody Transfer to Neonates from Cord Blood and Breast Milk -
 ADP-Ribosylation of Cytidine: A Novel Nucleic Acid Modification Reversed by NADAR Hydrolases
ADP-Ribosylation of Cytidine: A Novel Nucleic Acid Modification Reversed by NADAR Hydrolases -
From Surface Colonies to Internal Contamination: A Comprehensive Investigation of Alternaria alternata Growth, Toxinogenesis, and Mycotoxin Migration Dynamics in Cherry Tomato Fruit Matrix
From Surface Colonies to Internal Contamination: A Comprehensive Investigation of Alternaria alternata Growth, Toxinogenesis, and Mycotoxin Migration Dynamics in Cherry Tomato Fruit Matrix
Journal Description
Toxins
- Open Access— free for readers, with article processing charges (APC) paid by authors or their institutions.
- High Visibility: indexed within Scopus, SCIE (Web of Science), PubMed, MEDLINE, PMC, Embase, CAPlus / SciFinder, AGRIS, and other databases.
- Journal Rank: JCR - Q1 (Toxicology) / CiteScore - Q1 (Toxicology)
- Rapid Publication: manuscripts are peer-reviewed and a first decision is provided to authors approximately 19.5 days after submission; acceptance to publication is undertaken in 2.8 days (median values for papers published in this journal in the second half of 2025).
- Recognition of Reviewers: reviewers who provide timely, thorough peer-review reports receive vouchers entitling them to a discount on the APC of their next publication in any MDPI journal, in appreciation of the work done.
- Sections: published in 6 topical sections.
Latest Articles
Highly Accessed Articles
Latest Books
E-Mail Alert
News
Topics
Deadline: 31 March 2026
Deadline: 31 August 2026
Deadline: 1 July 2027
Deadline: 31 July 2027
Conferences
Special Issues
Deadline: 31 March 2026
Deadline: 31 March 2026
Deadline: 31 March 2026
Deadline: 31 March 2026






























